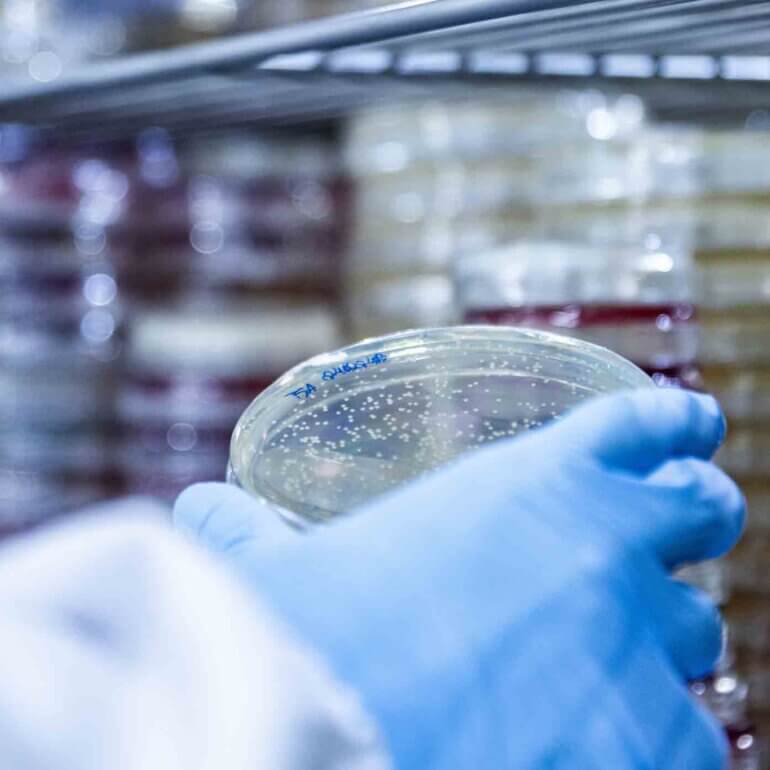
Lori Paula Fotografia Biotecnologia 22

biotecnologia
Portfolio
biotecnologia
fotografia industrial em indústria biotecnológica
quem tem medo de bactérias?
micro organismos sob controle, e o melhor, funcionais
Fotografia em indústria biotecnológica é daquelas coisas que parecem só existir em filmes.
Eu sou entusiasta de tecnologia no geral e sonhos meus de menino hoje em dia se concretizam, como poder falar em vídeo com qualquer pessoa de qualquer lugar do mundo.
Agora, quando vi nos anos 90, trabalhando com design de embalagem, os caminhos que a biotecnologia estava tomando era sensacional.
Poder estar hoje em dia em contato com esse mundo por meio da fotografia é simplesmente demais.
Fotografei algumas das maiores empresas de biotecnologia da América Latina e fiquei de cara impressionado com o portfólio de soluções com o uso de bactérias, com a sua versatilidade.
Tecnologias voltadas para melhoramentos sociais e industriais, já que se aplicam desde o universo agro, o tratamento de efluentes até o segmento de óleo e gás e cosméticos.












fotografia em laboratório
Parece cenário de filme
Para um leigo [ como eu ] , não tem como entrar em uma empresa dessas e não ficar impressionado com as instalações e seus equipamentos, e são muitos.
O olhar aqui para os cuidados para entrar nos laboratórios, as pessoas e suas vestimentas, os equipamentos de estudo, a área de produção e o próprio galpão em si. Um verdadeiro – parque de diversões visuais – para olhares atentos.
Para mim é um prazer enorme poder trabalhar com esse tipo de fotografia. É por essa e por outras que coloco 100% do meu foco na indústria e seu multiverso.
Saiba mais sobre como a fotografia industrial pode ajudar a vender o seu produto.